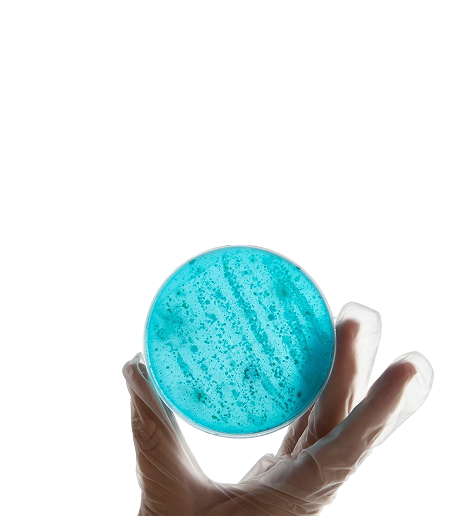
Контроль качества

сила природы и биотехнологии
для тебя и твоей семьи!
Продукция МейТан – это красота, здоровье, гигиена и уход за домом для всей семьи.
Производство сертифицировано по международным стандартам GMP и ISO 9001, а продукция производится на контрактных заводах России, Китая, Индии и других стран.

Природная сила
для вашего здоровья
Компания МейТан родом из Сибири. Мы верим в силу природы и безграничные возможности человека.
Мы создаем уникальный продукт на основе многолетнего опыта китайского, индийского, алтайского целительства и современных биотехнологий.
120+
тысяч довольных
покупателей
покупателей
22
года на рынке красоты
и здоровья
и здоровья
687
наименований
в ассортименте
в ассортименте
Контроль качества
Контролируем каждый этап производства продукции для
безупречного качества
Чистота и безопасность
100% чистый состав без химии и красителей

Доступное премиум-качество
Мы создаем эталонные продукты, делая ставку на
эффективные формулы, а не на громкий бренд.



